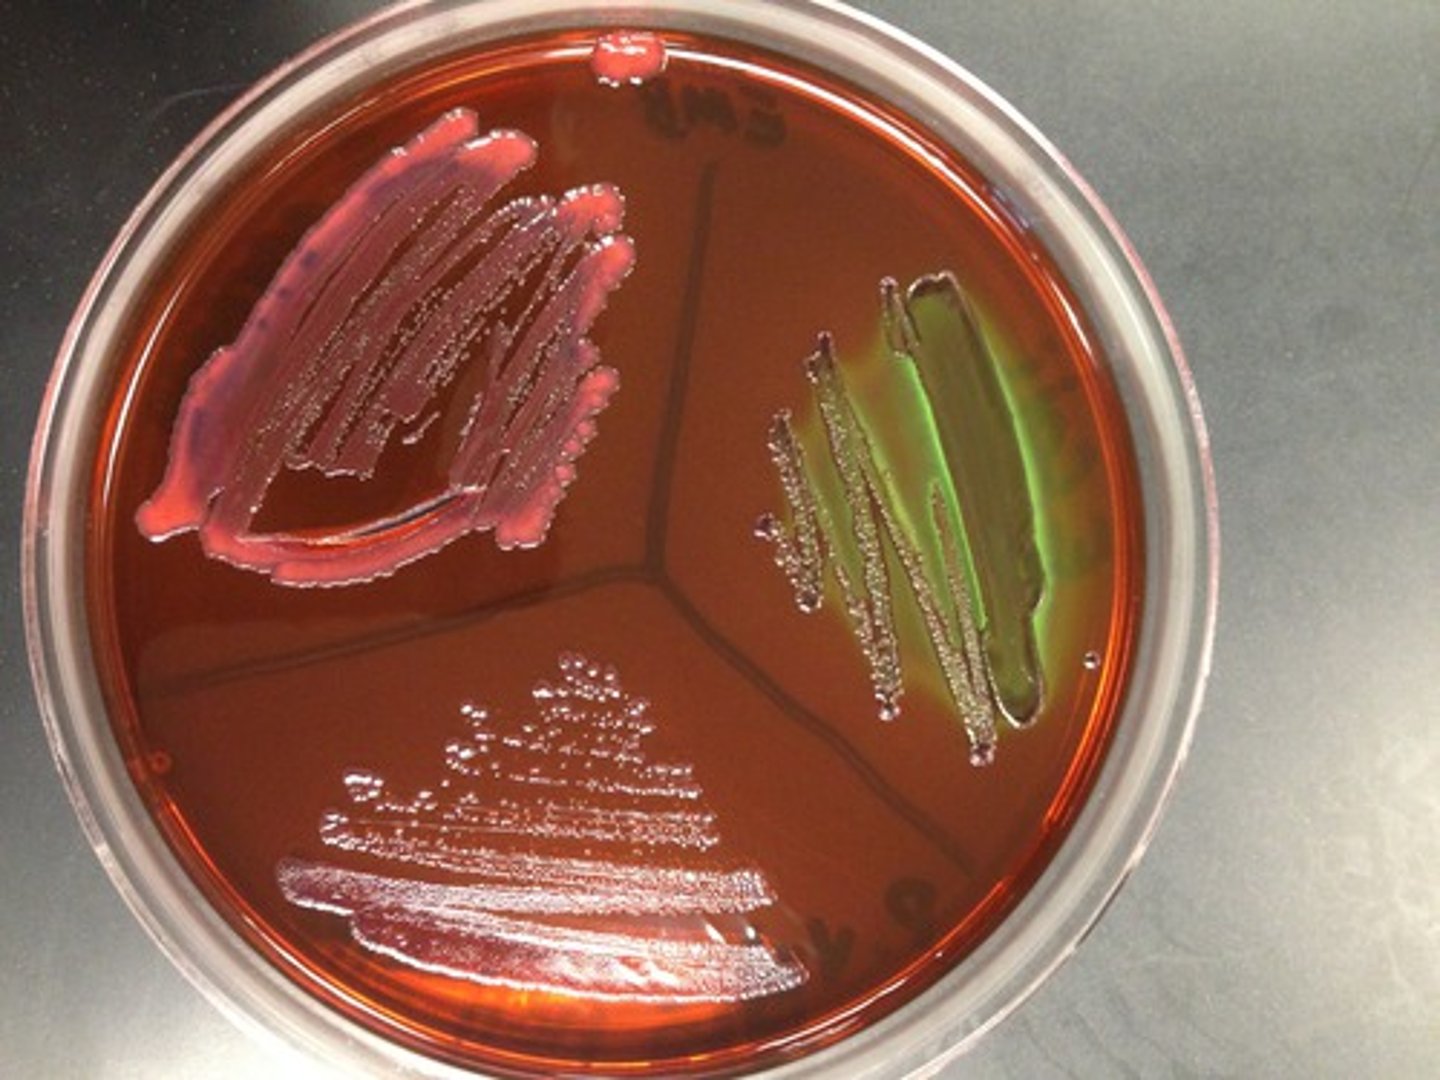
<p>A group of generally harmless microorganisms in human intestines that can serve as an indicator species for potentially harmful microorganisms associated with contaminated sewage</p>
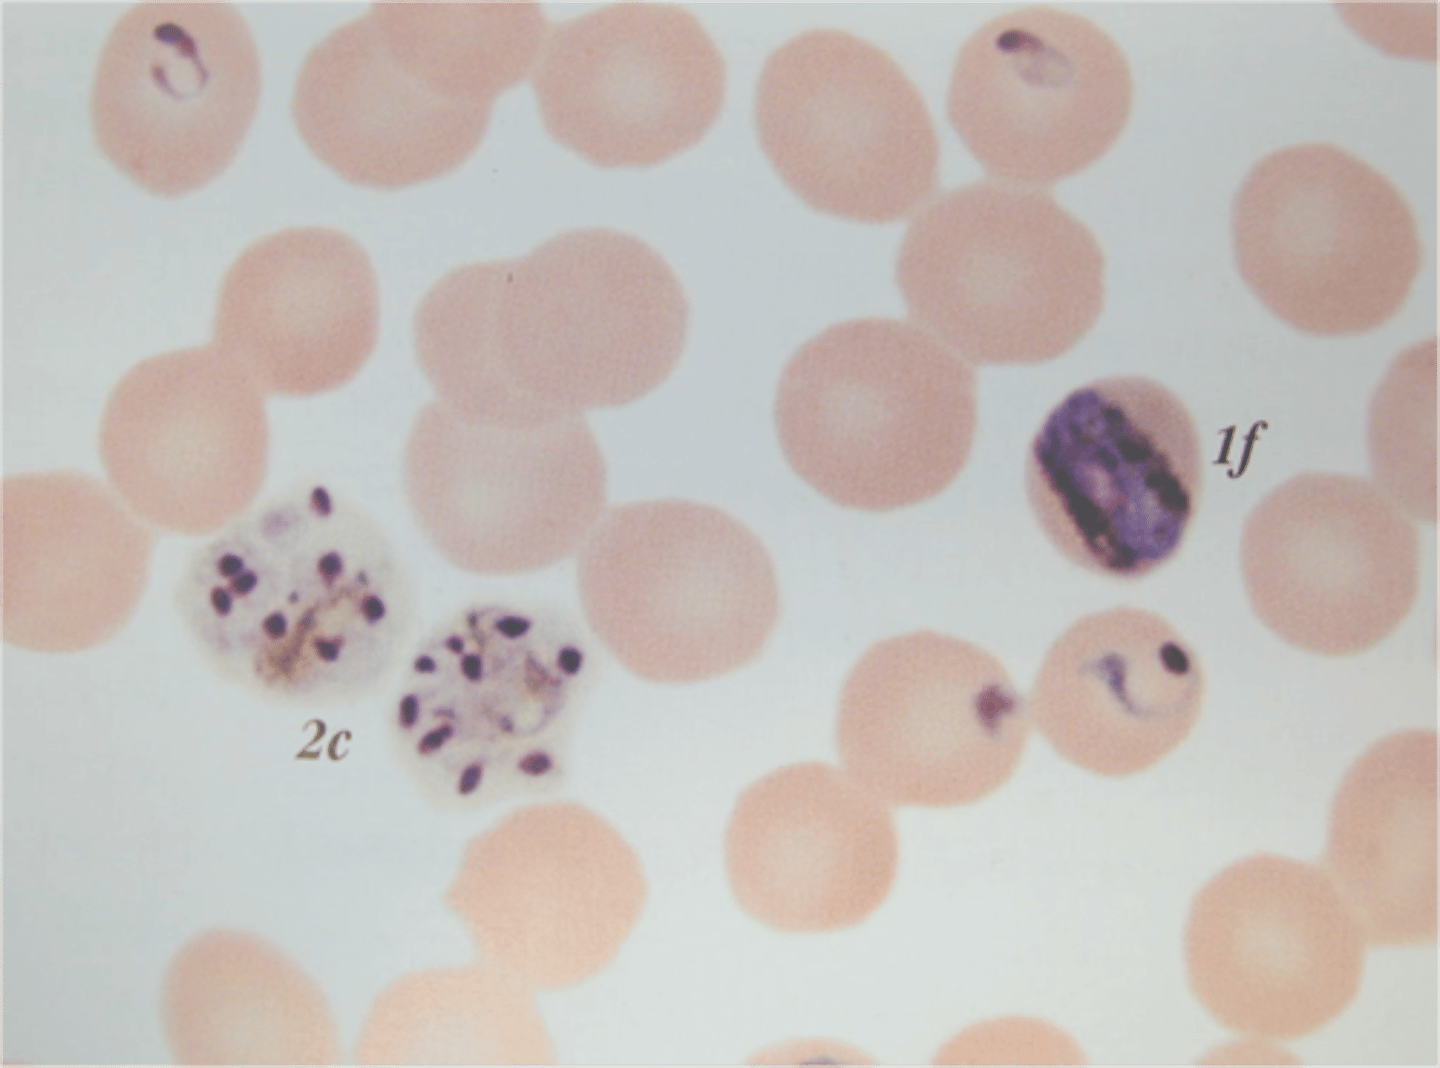
<p>This disease is commonly associated with poverty and is spread by mosquitos. Each year 1-3 million people mostly in sub-saharan Africa die of this diesase and hundreds of millions are infected. Bad air.</p>

1/107
Looks like no tags are added yet.
Name | Mastery | Learn | Test | Matching | Spaced | Call with Kai |
|---|
No analytics yet
Send a link to your students to track their progress
Algal Bloom
An immediate increase in the amount of algae and other producers that results from a large input of a limiting nutrient.

Biochemical Oxygen Demand (BOD)
Amount of oxygen required by aquatic bacteria to decompose given load of organic waste; a measure of water pollution.

Biomagnification
The increase in chemical concentration in animal tissues as the chemical moves up the food chain. the higher the trophic level, the higher the concentration

example of biomagnification
eggshell thinning and developmental deformities in top carnivores of the higher trophic levels
effects of biomagnification on humans
include issues with the reproductive, nervous and circulatory systems
substances that bioaccumulate and have significant environmental impacts
DDT, mercury, and PCBs (polychlorinated biphenyls)
Polychlorinated biphenyls (PCBs)
A group of industrial compounds used to manufacture plastics and insulate electrical transformers, and responsible for many environmental problems.

Bioaccumulation
the selective absorption and concentration of elements or compounds by cells in a living organism, most commonly fat-soluble compounds

Boom
Temporary floating barrier used to contain an oil spill.
Bubonic Plague
Disease brought to Europe from the Mongols during the Middle Ages. It killed 1/3 of the population and spread through the bite of an organism inflected with the plague bacteria (rats and fleas) or through contact with contaminated fluids or tissues

Cholera
An acute intestinal infection caused by ingestion of bacteria contaminated water or food

Composting
A process that allows the organic material in solid waste (such as food scraps, paper, yard waste) to be decomposed and reintroduced into the soil, often as fertilizer.

drawbacks of composting
odor and rodents, can attract predatory animals such as bears
how can e-waste be reduced?
by recycling and reusing
negative impacts of e-waste
may contain hazardous chemicals, including heavy metals such as lead and mercury, which can leach from landfills into groundwater if they are not disposed of properly
landfill mitigation strategies
range from burning waste for energy to restoring habitat on former landfills for use as parks
negative impacts on coral reefs
increasing ocean temperatures, sediment runoff, and destructive fishing practices have caused damage to coral reefs
Coral Bleaching
A phenomenon in which algae inside corals die, causing the corals to turn white.

Dead Zone
In a body of water, an area with extremely low oxygen concentration and very little life. (ex. end of Mississippi River) caused by increased nutrient pollution

Decomposition
A chemical reaction that breaks down compounds into simpler products. AB->A+B

effects of oil spills
cause organisms to die from the hydrocarbons in the oil; oil that floats on the surface can coat the feathers of birds and fur of marine mammals; oil that sinks to the ocean floor can kill bottom-dwelling organisms
economic consequences of oil spills
can negatively impact the fishing industry and tourism
Disperant
Improve the separation of particles and to prevent settling or clumping (ex. cleaning up an oil spill in an ocean & dumping chemicals in the ocean to clean it up)
Dose Response Curve
Describes the magnitude of the response of an organism, as a function of exposure (or doses) to a particular toxin or drug after a certain exposure time

why is it difficult to establish a cause and effect between pollutants and human health issues?
because humans experience exposure to a variety of chemicals and pollutants
E-Waste
Discarded electronic equipment such as computers, cell phones, television sets, etc.

Endocrine Disruptors
chemicals that interfere with the normal functioning of hormones in an animal's body

impacts of endocrine disruptors
can lead to birth defects, developmental disorders, and gender imbalances in fish and other species
examples of endocrine disruptors
pesticides (i.e., DDT), PCBs, Bisphenol A (BPA) in plastic bottles

Eutrophication/Cultural Eutrophication
Body of water becomes overly enriched with minerals and nutrients which induce excessive growth of algae. May result in oxygen depletion.

how do algal blooms impact aquatic environments?
excess algae blocks sunlight from entering the body of water; plants below the surface die off, as bacteria decompose the dead plants, they consume oxygen, reducing the dissolved oxygen levels and leading to large die-offs of fish and other aquatic organisms
Fecal Coliform Bacteria
A group of generally harmless microorganisms in human intestines that can serve as an indicator species for potentially harmful microorganisms associated with contaminated sewage
Great Pacific Garbage Patch
Patch of solid waste the size of Texas floating in the currents of the North Pacific gyre, mostly consisting of plastics.

Hypoxic waterways
Pertaining to a low level of dissolved oxygen

Incineration
The process of burning waste materials to reduce volume and mass, sometimes to generate electricity or heat

Advantages of solid waste incineration
- volume of waste reduced by 90%
- waste heat can be used
Disadvantages of solid waste incineration
- toxic emissions (polyvinyl chloride, dioxin)
- scrubbers and electrostatic precipitators needed
- need to properly dispose of waste ash leftover
illegal disposal of waste
some items are not accepted in sanitary landfills and may be disposed of illegally, leading to environmental problems
why are thrown out rubber tires a problem?
when lift in piles, water can accumulate in them and become breeding grounds for mosquitos that can spread disease
Indicator Species
Species that serve as early warnings that a community or ecosystem is being degraded.

Leachate
polluted liquid produced by water passing through buried wastes in a landfill

Malaria
This disease is commonly associated with poverty and is spread by mosquitos. Each year 1-3 million people mostly in sub-saharan Africa die of this diesase and hundreds of millions are infected. Bad air.
Mangroves
Tropical trees that grow along coasts and help maintain the health of coastal environments.

Maximum Containment Level (MCL)
The standard for safe drinking water established by the EPA under the Safe Drinking Water Act.

MERS
Middle East Respiratory Syndrome is a viral respiratory illness transferred from animals to humans
Mesothelioma
Rare malignant tumor arising in the pleura and associated with asbestos exposure.

how does mercury change in aquatic environments?
when elemental sources of mercury enter aquatic environments, bacteria in the water convert it to highly toxic methylmercury

Methylmercury
A highly toxic heavy metal that biomagnifies in aquatic ecosystems and contaminates humans largely through eating of [shell]fish; damages the central nervous system (esp. children/embryos) and leads to impaired coordination and sense of touch/taste/sight.
![<p>A highly toxic heavy metal that biomagnifies in aquatic ecosystems and contaminates humans largely through eating of [shell]fish; damages the central nervous system (esp. children/embryos) and leads to impaired coordination and sense of touch/taste/sight.</p>](https://knowt-user-attachments.s3.amazonaws.com/9a69885e-2a59-4488-a53d-dadcf61ff10c.jpg)
Nonpoint Source
A widely spread source of pollution that is difficult to link to a specific point of origin; are diffused, such as pesticide spraying or urban runoff

Oligotrophic waterways
A condition of a lake or other body of water characterized by low nutrients, low productivity, stable algae populations and high dissolved oxygen levels in the water column.

anthropogenic causes of eutrophication
agricultural runoff and wastewater release
Oxygen Sag Curve
The curve obtained when the concentration of dissolved oxygen in a river into which sewage or some other pollutant has been discharged is plotted against the distance downstream from the sewage outlet

impacts of industry on drinking water supply
heavy metals used for industry, especially mining and burning of fossil fuels, can reach the groundwater, impacting the drinking water supply
impact of litter on aquatic ecosystems
litter is unsightly and can create intestinal blockage and choking hazards for wildlife and introduce toxic substances to the food chain

impact of increased sediment in waterways
can reduce light infiltration, which can affect primary producers and visual predators; sediment can also settle, disrupting habitats
Pathogen
A bacterium, virus, or other microorganism that can cause disease; they adapt to take advantage of opportunities to infect and spread through human populations

does the appearance of sanitary conditions prohibit pathogens?
no; specific pathogens can occur in many pathogens regardless of the appearance of sanitary conditions
impact of climate change on disease
as equatorial-type climate zones spread north and south, pathogens, infectious diseases, and any associated vectors are spreading into theses areas where the disease has not previously been known to occur
Vectors
An organism that transmits disease by conveying pathogens from one host to another; such as a mosquito

infectious disease
A disease that is caused by a pathogen and that can be spread from one individual to another.
why poverty-stricken, low-income areas or more susceptible or vulnerable to infectious disease
they often lack sanitary waste disposal and have contaminated drinking water supplies
Persistent Organic Pollutants (POPs)
synthetic, carbon-based chemical compounds that persist in the environment and retain biological activity for a long time. Now banned, DDT, PCBs (liquid insulators in electric transformers), and dioxins (a byproduct of herbicide production)

Why are Persistent Organic Pollutants (POPs) and environmental concern
they do not easily break down and can be toxic to organisms because they are soluble in fat, which allows them to accumulate in organisms' fatty tissues; they can travel over long distances via wind and water before being redeposited
point source pollutants
A specific source of pollution that can be identified; a single, identifiable source of a pollutant such as a smokestack, waste discharge pipe, or oil tanker

Polychlorinated Biphenyls (PCBs)
A group of industrial compounds used to manufacture plastics and insulate electrical transformers, and responsible for many environmental problems.

Primary Treatment of sewage
First step of sewage treatment; eliminates most large objects and particulate material from raw sewage using grates, screens, and gravity (settling).

Range of Tolerance
Range of chemical and physical conditions that must be maintained for populations of a particular species to stay alive and grow, develop, and function normally

Optimum range of tolerance
Carries the most organisms the most efficiently

zone of physiological stress
zone where small numbers can survive these difficult conditions

zone of intolerance
zone where organisms cannot survive

Recycling
certain solid waste materials are processed and converted into new products

Advantages of recycling
one way to reduce the current global demand on minerals
disadvantages of recycling
energy-intensive, costly and only 10% of plastic bottles are actually recycled; mixed-plastic and mixed-material products make recycling very difficult
Runoff
Part of the water cycle where an excess of water runs down and does not sink into the soil and eventually makes it to the rivers, lakes, and oceans.

Safe Drinking Water Act
Set maximum contaminant levels for pollutants that may have adverse effects on human health.

Sanitary Municipal Landfill
Waste is isolated from the environment until it is safe; it is composed of a bottom liner (plastic or clay), a storm water collection system, a leachate collection system, a cap, and a methane collection system

Problems with landfills
noise, traffic, dust, waste decomposes slowly, groundwater contamination, Greenhouse gas emissions (methane)

electronic waste (e-waste)
Discarded electronic products such as computers, monitors, printers, DVD players, cell phones, and other devices. Heavy metals in these products mean that this waste may require treatment as hazardous waste.

factors in landfill decomposition
include the composition of the trash and conditions needed for microbial (bacterial) decomposition of the waste
ocean dumping
the act of dumping trash & wastes into the ocean; some countries do this, which leads to large floating island of trash in the ocean; threatens marine life

Methane recovery system
as organic waste in landfills decompose, they release methane gas; that methane can be captures and burned to heat water; the steam turns a turbine and generates electricity; also reduces landfill volume

solid waste
any discarded solid material that is not a liquid or gas; it is generated in domestic, industrial, business, and agricultural sectors
where is solid waste disposed of the most?
landfills
Severe Acute Respiratory Syndrome (SARS)
form of pneumonia; Environmental factors on the SARS epidemic: air temperature, passage of time and multiplicative effect of hospital infection; transferred by inhaling or touching infected fluids

Secondary Treatment
Bacterial (biological) decomposition of suspended particulates and dissolved organic compounds that remain after primary sewage treatment; gets converted into carbon dioxide and inorganic sludge which settles in the bottom of the tank

aeration tank
secondary part of sewage treatment, where water is mixed with oxygen and bacteria which breaks down the organic matter

Sedimentation
The process in which soil particles and decaying organic matter accumulate in layers on the ground or at the bottom of large bodies of water, contributing to the formation of sedimentary rock

Septage
The middle layer of fairly clear water (often in a septic tank), contains large quantities of bacteria and may also contain pathogenic organisms and inorganic nutrients such as nitrogen and phosphorous.
Septic System
A relatively small and simple sewage treatment system, made up of a septic tank and a leach field, often used for homes in rural areas.

Septic Tank
A large container that receives wastewater from a house as part of a septic system

Sludge
Toxic chemicals, infectious agents, and settled solids removed from wastewater at a sewage treatment plant.
Tertiary Treatment of sewage
Highest form of wastewater treatment that includes removal of nutrients, organic and solid material, along with biological & chemical polishing.

how is sewage treated in the last step prior to discharge?
the treated water is exposed to one or more disinfectants (usually chlorine, ozone or UV light) to kill bacteria
Lethal Dose-50% (LD50)
The dose of a chemical that is lethal to 50 percent of the population of a particular species

Thermal Pollution
A temperature increase in a body of water that is caused by human activity and that has a harmful effect on water quality and on the ability of that body of water to support life.

Thermal Shock
Many species die because a dramatic change in temperature puts them outside their natural range of temps.
Clean Water Act
(CWA, 1972) set maximum permissible amounts of water pollutants that can be discharged into waterways; aims to make surface waters swimmable and fishable

Tuberculosis
An infectious disease that may affect almost all tissues of the body, especially the lungs.

Wastewater
Any water that has been used by humans. This includes human sewage, water drained from showers, tubs, sinks, dishwashers, washing machines, water from industrial processes, and stormwater runoff.

Water Pollution
The contamination of streams, rivers, lakes, oceans, or groundwater with substances produced through human activities.
